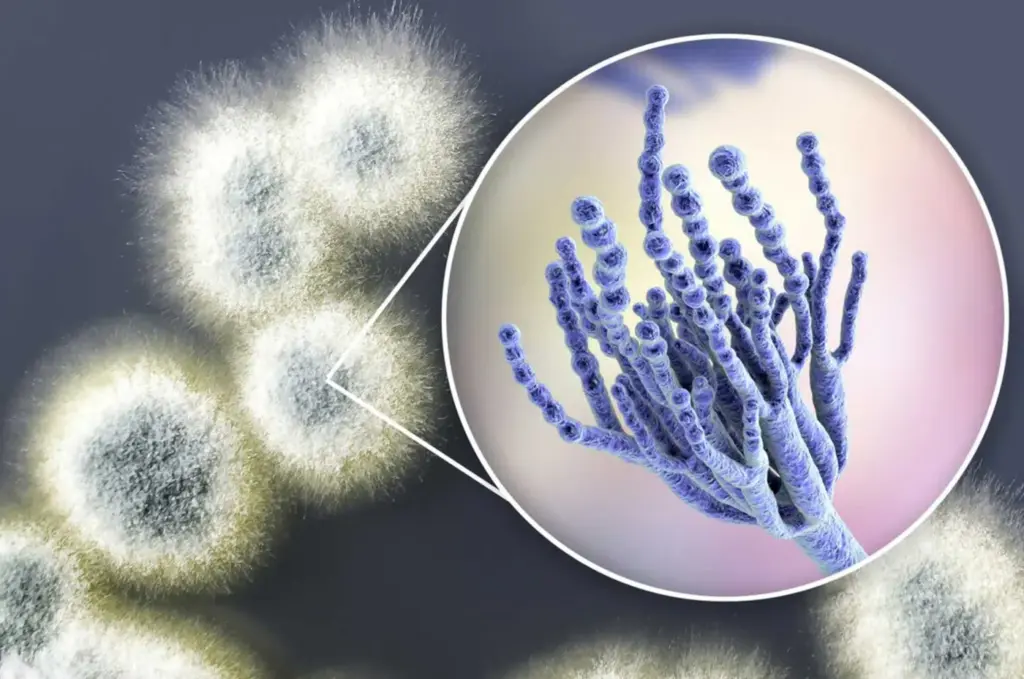

Schimmelfrei in Sekunden
- Nie wieder Schimmel
- Wirkt ab der 1. Sekunde
- Sicher für Mensch und Tier
- neuste Wissenschaft
Ärzte schlagen Alarm: Warum herkömmliche Schimmel-Mittel Ihre Lungen belasten – und wie ein Münchner Chemiker die Lösung fand
Die gesundheitliche Gefahr im Verborgenen: Während herkömmliche Sprays den Schimmel nur oberflächlich bleichen und aggressive Dämpfe freisetzen, packt Jürgen Neuhausers neue Gel-Formel das Problem an der Wurzel.
Advertorial: Manuela Küppers | veröffentlicht vor 3 Tagen

Die unsichtbare Belastung: Warum herkömmliche Schimmelentfernung ein gefährlicher Trugschluss ist
In den meisten Haushalten wird Schimmel als ästhetisches Problem behandelt. Doch die Wissenschaft zeichnet ein anderes Bild:
Der sichtbare Fleck an der Wand ist oft nur die Spitze des Eisbergs.
Aktuelle klinische Studien belegen, dass die gesundheitliche Belastung nicht durch die sichtbare Verfärbung entsteht, sondern durch die unsichtbare Sporenkonzentration in der Raumluft. (Besonders gefährlich bei Wasserdampf in der Dusche bzw. Badezimmer)
Wer hier falsch reagiert, beseitigt zwar die Optik, lässt das eigentliche Gesundheitsrisiko aber unberührt.
Das Problem der „kosmetischen Reinigung“
Die meisten handelsüblichen Sprays basieren auf Natriumhypochlorit (Chlor). Diese Mittel haben eine entscheidende Schwäche, die das Problem oft verschlimmert:
Bleichen statt Abtöten: Chlor entzieht dem Schimmelpilz die Farbe. Die Fuge sieht wieder weiß aus, doch das Myzel – das wurzelartige Geflecht im Inneren des Materials – bleibt vital und wächst im Verborgenen weiter.
Der Kapillar-Effekt: Dünnflüssige Sprays können aufgrund ihrer Oberflächenspannung nicht tief genug in Silikon oder Putz eindringen. Sie verdunsten an der Oberfläche, während die Wurzel unangetastet bleibt.
Reaktive Zunahme: Nach der Behandlung mit chlorhaltigen Mitteln kehrt der Schimmel oft aggressiver zurück, da die verbliebene Feuchtigkeit im Material dem Myzel neue Nahrung bietet.
Warum Schrubben kontraproduktiv ist
Der instinktive Griff zur Bürste ist eine der riskantesten Reaktionen.
Durch die mechanische Reibung werden die trockenen Schimmelsporen massiv aufgewirbelt.
Diese Partikel sind so fein, dass sie Stunden in der Raumluft verbleiben, sich in Textilien festsetzen und tief in die Atemwege gelangen können.
Mediziner warnen: Eine falsche Reinigungstechnik erhöht die Sporenbelastung in der Wohnung kurzzeitig um das bis zu 20-Fache!
Der technologische Wendepunkt
Um diesen Teufelskreis aus oberflächlicher Bleiche und gefährlichen Sporenwirbeln zu durchbrechen, war ein grundlegend neuer physikalischer Ansatz erforderlich.
Die Herausforderung für die Forschung war klar:
Es musste ein Medium entwickelt werden, das die Oberflächenspannung von Silikon und Fugenmörtel überwindet und gleichzeitig schwer genug ist, um eine Tiefenextraktion zu ermöglichen – ohne dabei wie ein gewöhnliches Spray abzulaufen.
Genau an diesem Punkt setzte der Münchner Chemiker und Experte für Gebäudeschutz, Jürgen Neuhauser, an.
Seine jahrelange Erfahrung in der Sanierung von Härtefällen lehrte ihn, dass man Schimmel nicht mit Flüssigkeiten bekämpfen kann, die nach Sekunden verdunsten oder weglaufen.
Seine Lösung basiert auf einer hochviskosen Adhäsions-Technologie, die nun erstmals für Privathaushalte zugänglich ist: NuroClean
Warum funktioniert NuroClean so gut?
NuroClean bricht das physikalische Scheitern herkömmlicher Reiniger durch eine aktive Tiefen-Gel-Technologie. In drei Schritten wird der Schimmel nicht nur gebleicht, sondern extrahiert:
Die Mikro-Haft-Matrix: In der Fachsprache thixotrop genannt – für Sie bedeutet es: Das Gel besiegt die Schwerkraft. Es klammert sich fest an senkrechte Fugen und Silikon. Während Sprays sofort wirkungslos ablaufen, bleibt NuroClean exakt auf dem Schmutzherd sitzen.
Molekulare Infiltration: Schimmel ist wie ein Eisberg. Seine Wurzeln (Hyphen) bohren sich millimeterweit ins Material. Per Diffusion infiltriert das Gel diese Poren und erreicht Schichten, die für normale Mittel unerreichbar sind.
Der Extraktions-Effekt: In 10–20 Minuten löst das Gel den Schimmel-Kern molekular auf. Es neutralisiert Gerüche und zieht den jahrelangen Dreck buchstäblich aus der Tiefe der Wand ans Licht.
Das Ergebnis: Porentiefe Reinheit, weil die Wurzel vernichtet wurde.
Wo Sie NuroClean überall einsetzen können:
Egal ob im Bad, in der Küche oder im Keller – NuroClean haftet dort, wo andere Reiniger einfach wirkungslos weglaufen.
Dusche & Badewanne: Es kriecht tief in die Silikonfugen und zieht den schwarzen Schimmel-Kern heraus, statt ihn nur zu bleichen.
Fliesen-Zwischenräume: Macht vergilbte oder schlammig-dunkle Zementfugen wieder strahlend weiß.
Fensterrahmen: Stoppt den Pilz an Kältebrücken, bevor er das Material oder die Bausubstanz zerfressen kann.
Senkrechte Wände: Da das Gel extrem haftet, ist es perfekt für Kellerwände oder Ecken, an denen flüssige Sprays sofort versagen.
Waschküche & Küche: Überall, wo Feuchtigkeit steht und sich dieser typische, muffige Geruch ausbreitet.
Kurz gesagt: Wenn es feucht ist, festklebt und schimmelt, ist NuroClean die Lösung, die bleibt, bis die Gefahr wirklich weg ist.

Ist NuroClean sicher für Mensch und Umwelt?
Ein klares Ja. NuroClean wurde gezielt für den Einsatz in bewohnten Innenräumen entwickelt, um die Belastung so gering wie möglich zu halten:
Schutz der Atemwege: Im Gegensatz zu Sprays entstehen bei der Anwendung keine feinen Aerosol-Nebel. Es gibt kein Stechen in den Augen und keine beißenden Chlor-Dämpfe, die stundenlanges Lüften erzwingen.
Sanft zu Oberflächen: Die Formel ist so abgestimmt, dass sie den Schimmel radikal vernichtet, aber moderne Bad-Armaturen, Fliesen und empfindliches Silikon nicht angreift oder porös macht.
Keine gefährlichen Rückstände: Nach der kurzen Einwirkzeit wird das Gel einfach feucht abgewischt. Was bleibt, ist eine klinisch reine Oberfläche – ohne chemische Filme, die für Kinder oder Haustiere bedenklich wären.
Das sagen Personen, die NuroClean getestet haben:
„Endlich atmet meine Familie wieder auf“ „Ich habe jahrelang versucht, den schwarzen Schimmel in unserer Dusche mit Billig-Sprays aus dem Supermarkt zu bekämpfen. Es kam immer wieder. Als meine Tochter anfing, ständig zu husten, wurde mir klar: Wir brauchen eine echte Lösung. NuroClean hat das Silikon nicht nur oberflächlich gereinigt, sondern den Dreck regelrecht ‘herausgezogen’. Seit 4 Monaten ist alles strahlend weiß und die Luft fühlt sich endlich wieder rein an.“ — Sabine M., zweifache Mutter
„Medizinisch gesehen die einzig logische Wahl“ „Als Mediziner sehe ich oft die Folgen von Schimmelbelastung: Asthma, Allergien und chronische Müdigkeit. Das Problem herkömmlicher Chlor-Reiniger ist, dass sie die Sporen nur bleichen, aber nicht eliminieren. Die Patienten atmen die unsichtbaren Gifte weiter ein. Die Gel-Formel von NuroCleanist deshalb so effektiv, weil sie lange genug einwirkt, um das Myzel – die Wurzel des Pilzes – abzutöten. Wer seine Atemwege schützen will, sollte nicht schrubben, sondern die Ursache entfernen.“ — Dr. med. Christian L., Facharzt für Pneumologie
„Der Endgegner für hartnäckige Fugen“ „Ich bin Handwerker und habe schon alles gesehen. Normalerweise hilft bei tiefsitzendem Schimmel nur eines: Rausreißen und neu verfugen. Ich war extrem skeptisch, ob ein Gel das wirklich schafft. Aber NuroClean haftet so brutal an der Wand, dass es den Schimmel selbst aus den porösesten Stellen zieht. Ich habe es im Keller an einer feuchten Ecke getestet – 30 Minuten einwirken, abwischen, fertig. Das spart Stunden an Arbeit und Nerven.“ — Bernd S., Fliesenlegermeister
Ist die Anwendung kompliziert?
Nein – einfacher geht es kaum. In 3 Schritten zur Schimmelfreiheit
Schimmel entfernen war nie einfacher. NuroClean erledigt die Arbeit, während Sie entspannen:
Auftragen: Gel direkt auf die trockene, betroffene Stelle geben.
Einwirken: 20–30 Minuten wirken lassen (das Gel zieht von selbst in die Tiefe).
Abspülen: Einfach feucht abwischen oder abspülen. Fertig.
UPDATE: Bis zu 75 % Rabatt (Nur heute!)
Aufgrund der enormen Nachfrage gilt aktuell ein exklusiver Sonderverkauf: Sichern Sie sich NuroClean™ nur heute mit 75 % Rabatt.
Achtung: Das Angebot gilt nur für das heutige Kontingent und endet, sobald der Vorrat erschöpft ist. Wenn weg, dann weg!
Warum Qualität keine Kompromisse duldet
„Die Nachfrage nach NuroClean™ ist aktuell außergewöhnlich hoch“, erklärt Entwickler Jürgen Neuhauser. Doch für den Chemiker zählt wissenschaftliche Präzision mehr als schneller Profit.
Um die maximale Tiefenwirkung zu garantieren, bleibt Neuhauser konsequent:
Made in Germany: Produktion unter strengsten Kontrollen direkt vor Ort.
Labor-Garantie: Jede einzelne Charge wird vor dem Versand auf ihre molekulare Tiefenwirkung geprüft.
Präzisions-Formel: Die Wirkstoffe müssen exakt dosiert sein – nur so wird der Schimmel-Kern wirklich erreicht.
Klasse statt Masse: „Wir könnten billiger im Ausland produzieren, aber dann wäre es nicht mehr NuroClean™“, so Neuhauser.
Die Kehrseite dieser Exzellenz: NuroClean™ ist kein Massenprodukt. Allein in diesem Jahr war die Formel bereits mehrfach restlos ausverkauft. Sollte der Artikel im Shop gerade als „nicht verfügbar“ angezeigt werden, bitten wir um Geduld: In der Regel dauert es 3 bis 4 Wochen, bis die nächste laborgeprüfte Charge lieferbar ist.
Offenlegung Von Werbung: Diese Website und die Produkte und Dienstleistungen, auf die auf der Website verwiesen wird, sind Werbemarktplätze. Bei dieser Website handelt es sich um eine Werbung und nicht um eine Nachrichtenpublikation. Alle auf dieser Website verwendeten Fotos von Personen sind Modelle. Der Eigentümer dieser Website und der Produkte und Dienstleistungen, auf die auf dieser Website verwiesen wird, bietet lediglich einen Dienst an, über den Verbraucher Informationen erhalten und Vergleichen können. Marketing Disclosure: Diese Website ist ein Marktplatz. Als solcher sollten Sie wissen, dass der Eigentümer eine finanzielle Verbindung zu den auf der Website beworbenen Produkten und Dienstleistungen hat. Der Eigentümer erhält eine Zahlung, wenn ein qualifizierter Lead vermittelt wird, aber das ist auch schon alles. Haftungsausschluss: Die Auf Dieser Website Enthaltenen Informationen Sind Nicht Als Spezifischer Medizinischer Rat Gedacht Und Stellen Keinen Ersatz Für Eine Professionelle Behandlung Oder Diagnose Dar. Diese Aussagen Wurden Nicht Von Der FDA Bewertet. Dieses Produkt Ist Nicht Dazu Bestimmt, Krankheiten Zu Diagnostizieren, Zu Behandeln, Zu Heilen Oder Zu Verhindern. Die Ergebnisse Können Von Einer Person Zur Anderen Variieren. Wenn Sie Schwanger Sind, Stillen, Medikamente Einnehmen Oder Unter Ärztlicher Aufsicht Stehen, Konsultieren Sie Bitte Vor Der Anwendung Einen Arzt Oder Medizinisches Fachpersonal. Dieses Produkt Sollte Nur Gemäß Den Anweisungen Auf Dem Etikett Verwendet Werden. Konsultieren Sie Vor Der Anwendung Einen Arzt, Wenn Sie An Einer Schweren Krankheit Leiden Oder Verschreibungspflichtige Medikamente Einnehmen. Vor Der Verwendung Dieses Und Aller Anderen Nahrungsergänzungsmittel Sollte Der Rat Eines Arztes Eingeholt Werden. Alle Marken Und Urheberrechte Sind Eigentum Der Jeweiligen Inhaber Und Stehen In Keiner Verbindung Zu Diesem Produkt Und Werden Von Diesen Nicht Unterstützt. Diese Aussagen Wurden Nicht Von Der FDA Bewertet. Dieses Produkt Ist Nicht Dazu Bestimmt, Krankheiten Zu Diagnostizieren, Zu Behandeln, Zu Heilen Oder Zu Verhindern. Individuelle Ergebnisse Werden Variieren. Durch Die Nutzung Dieser Website Erklären Sie Sich Mit Der Datenschutzrichtlinie Und Allen Auf Dieser Website Abgedruckten Bedingungen Einverstanden. Ergebnisse können variieren.
Der Eigentümer hat eine finanzielle Verbindung zu den auf der Website beworbenen Produkten und Dienstleistungen. Das Produkt/der Service auf dieser Website wird von einem Unternehmen mit Sitz außerhalb der EU angeboten. Daher kann es schwierig sein, Ihr Recht auf ein 14-tägiges Widerrufsrecht auszuüben. Bitte lesen Sie die Rückgabebedingungen und die Widerrufsbelehrung für weitere Informationen.
Die Nutzung der Produkte und Inhalte dieser Website erfolgt auf eigene Verantwortung. Die Angebote richten sich ausschließlich an Personen über 18 Jahren.
*Dies ist ein gesponsertes Advertorial. Unsere Inhalte werden in Zusammenarbeit mit Zehenheld (HK Registernummer: 1299388) erstellt, um Ihnen interessante und relevante Informationen anzubieten. Das Angebot stellt keine medizinische Beratung dar und ist nicht dazu bestimmt, Krankheiten zu diagnostizieren, zu behandeln, zu heilen oder zu verhindern. Das Angebot ist kein Ersatz für Medikamente oder andere Behandlungen, die von einem Arzt oder Gesundheitsdienstleister verschrieben werden. Die Nutzer sollten vor Beginn einer Behandlung einen Arzt konsultieren. Wenn Sie schwanger sind, stillen, Medikamente einnehmen oder unter ärztlicher Aufsicht stehen, konsultieren Sie bitte vor der Nutzung einen Arzt oder medizinisches Fachpersonal.
Copyright © 2025 NuroClean Stories. All Rights Reserved.



